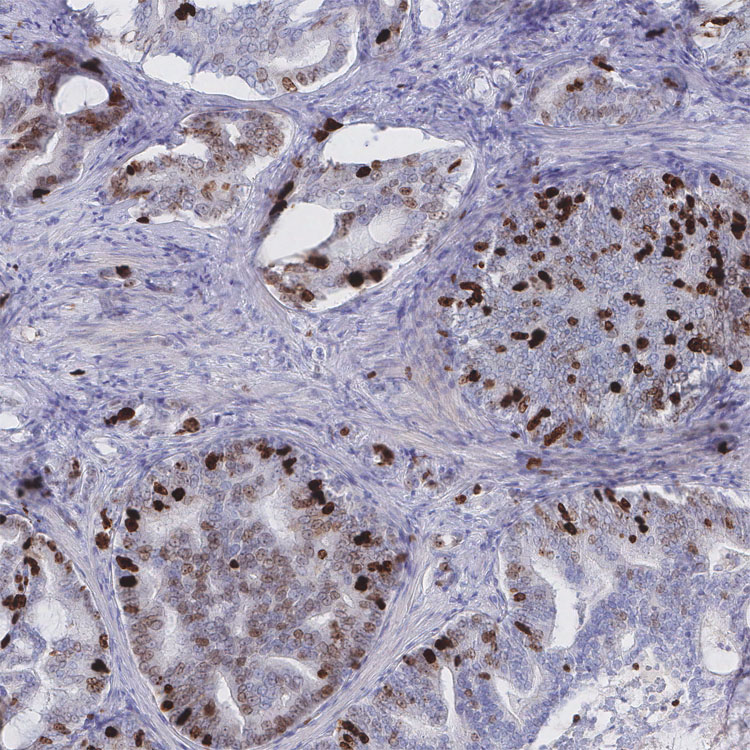

DictionaryProtein expressionMki67Mki67 - Detail 1
Mki67
High magnification of prostate cancer (adenocarcinoma) showing expression of the proliferation marker Ki-67 (MKI67). This particular tumor shows a moderate grade of proliferation with nuclear positive staining in a subset of the tumor cells.
Ki-67 (MKI67) - General marker for proliferation
The MKI67 gene encodes a widely known yet functionally poorly characterized protein called Ki-67 that specifically labels the nuclei and chromosomes of cells actively undergoing proliferation, but is not detected in cells that are in resting G0-phase. Thus, Ki-67 is a very general marker for actively proliferating cells and this characteristic has been heavily exploited in both research and clinical work. It is commonly used to assess the proliferative activity in tumors, which may be a measure of aggressiveness in certain types of cancer.
Show MKI67 in the protein atlas. |